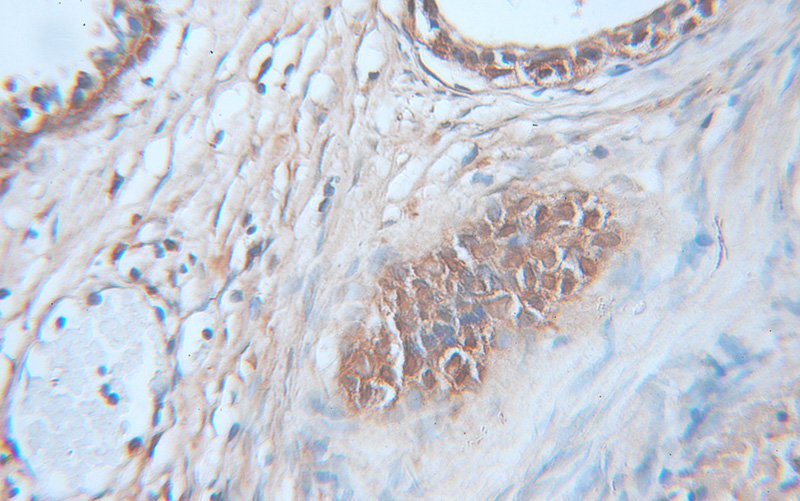
Immunohistochemical of paraffin-embedded human prostate cancer using Catalog No:108934(CAPG antibody) at dilution of 1:100 (under 10x lens)

-
Product Name
CAPG antibody
- Documents
-
Description
CAPG Rabbit Polyclonal antibody. Positive IP detected in mouse heart tissue. Positive WB detected in HeLa cells, HL-60 cells, mouse heart tissue, mouse thymus tissue, rat heart tissue, rat lung tissue. Positive IF detected in MCF-7 cells. Positive IHC detected in human prostate cancer tissue, human tonsillitis tissue. Observed molecular weight by Western-blot: 39-42kd
-
Tested applications
ELISA, WB, IHC, IF, IP
-
Species reactivity
Human,Mouse,Rat; other species not tested.
-
Alternative names
Actin regulatory protein CAP G antibody; AFCP antibody; CAPG antibody; Macrophage capping protein antibody; MCP antibody
-
Isotype
Rabbit IgG
-
Preparation
This antibody was obtained by immunization of CAPG recombinant protein (Accession Number: XM_011533122). Purification method: Antigen affinity purified.
-
Clonality
Polyclonal
-
Formulation
PBS with 0.1% sodium azide and 50% glycerol pH 7.3.
-
Storage instructions
Store at -20℃. DO NOT ALIQUOT
-
Applications
Recommended Dilution:
WB: 1:500-1:5000
IP: 1:200-1:2000
IHC: 1:20-1:200
IF: 1:20-1:200
-
Validations

HeLa cells were subjected to SDS PAGE followed by western blot with Catalog No:108934(CAPG antibody) at dilution of 1:1000
Immunohistochemical of paraffin-embedded human prostate cancer using Catalog No:108934(CAPG antibody) at dilution of 1:100 (under 10x lens)

Immunofluorescent analysis of MCF-7 cells, using CAPG antibody Catalog No:108934 at 1:50 dilution and Rhodamine-labeled goat anti-rabbit IgG (red). Blue pseudocolor = DAPI (fluorescent DNA dye).

IP Result of anti-CAPG (IP:Catalog No:108934, 4ug; Detection:Catalog No:108934 1:500) with mouse heart tissue lysate 4000ug.
-
Background
CapG (gelsolin-like actin-capping protein) is a member of the gelsolin superfamily proteins, which regulates actin filament length by capping or severing filaments. Studies have shown a role for CapG in regulating cell motility. The expression of CapG is upregulated under hypoxia and in turn increases the motility of cells. Recently it has been reported that the overexpression of CapG is associated with the progression of lung adenocarcinoma as well as lyphatic invasion status of cholangiocarcinoma, which may be used for prognosis of these tumors.(21908955,22155129)
-
References
- Zhang R, Zhou L, Li Q, Liu J, Yao W, Wan H. Up-regulation of two actin-associated proteins prompts pulmonary artery smooth muscle cell migration under hypoxia. American journal of respiratory cell and molecular biology. 41(4):467-75. 2009.
- Liao SH, Zhao XY, Han YH. Proteomics-based identification of two novel direct targets of hypoxia-inducible factor-1 and their potential roles in migration/invasion of cancer cells. Proteomics. 9(15):3901-12. 2009.
- Khositseth S, Pisitkun T, Slentz DH. Quantitative protein and mRNA profiling shows selective post-transcriptional control of protein expression by vasopressin in kidney cells. Molecular & cellular proteomics : MCP. 10(1):M110.004036. 2011.
- Morofuji N, Ojima H, Onaya H. Macrophage-capping protein as a tissue biomarker for prediction of response to gemcitabine treatment and prognosis in cholangiocarcinoma. Journal of proteomics. 75(5):1577-89. 2012.
- Kimura K, Ojima H, Kubota D. Proteomic identification of the macrophage-capping protein as a protein contributing to the malignant features of hepatocellular carcinoma. Journal of proteomics. 78:362-73. 2013.
- Ichikawa H, Kanda T, Kosugi S. Laser microdissection and two-dimensional difference gel electrophoresis reveal the role of a novel macrophage-capping protein in lymph node metastasis in gastric cancer. Journal of proteome research. 12(8):3780-91. 2013.
- Balakrishnan L, Bhattacharjee M, Ahmad S. Differential proteomic analysis of synovial fluid from rheumatoid arthritis and osteoarthritis patients. Clinical proteomics. 11(1):1. 2014.
- Kobayashi M, Nagashio R, Ryuge S. Acquisition of useful sero-diagnostic autoantibodies using the same patients'sera and tumor tissues. Biomedical research (Tokyo, Japan). 35(2):133-43. 2014.
Related Products / Services
Please note: All products are "FOR RESEARCH USE ONLY AND ARE NOT INTENDED FOR DIAGNOSTIC OR THERAPEUTIC USE"
